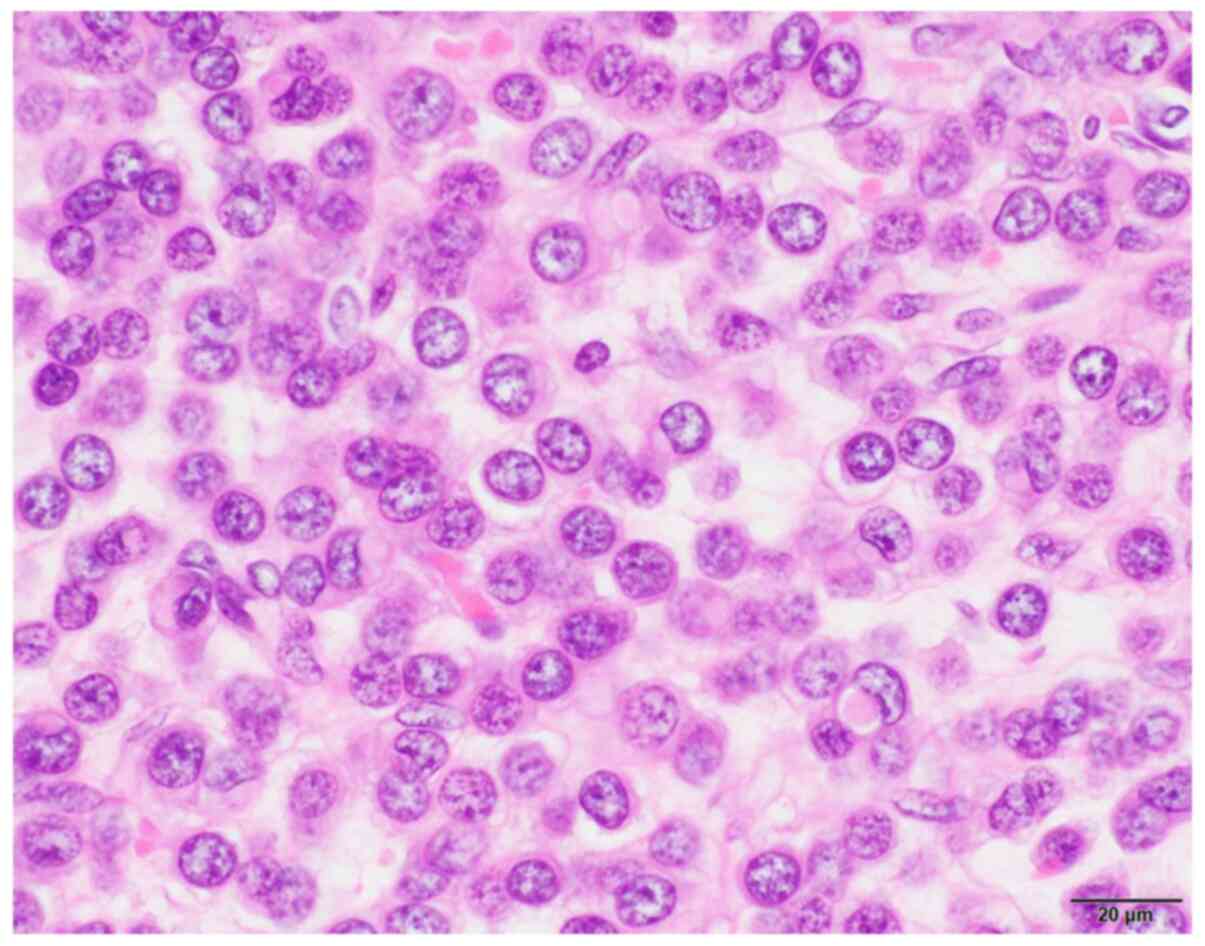

|
1
|
Kubeček O, Laco J, Špaček J, Petera J,
Kopecký J, Kubečková A and Filip S: The pathogenesis, diagnosis,
and management of metastatic tumors to the ovary: A comprehensive
review. Clin Exp Metastasis. 34:295–307. 2017.PubMed/NCBI View Article : Google Scholar
|
|
2
|
Omranipour R and Abasahl A: Ovarian
metastases in colorectal cancer. Int J Gynecol Cancer.
19:1524–1528. 2009.PubMed/NCBI View Article : Google Scholar
|
|
3
|
Alvarado-Cabrero I, Rodríguez-Gómez A,
Castelan-Pedraza J and Valencia-Cedillo R: Metastatic ovarian
tumors: A clinicopathologic study of 150 cases. Anal Quant
Cytopathol Histpathol. 35:241–248. 2013.PubMed/NCBI
|
|
4
|
Yadav BS, Sharma SC, Robin TP, Sams S,
Elias AD, Kaklamani V, Kelly Marcom P, Schaefer S and Morris GJ:
Synchronous primary carcinoma of breast and ovary versus ovarian
metastases. Semin Oncol. 42:e13–e24. 2015.PubMed/NCBI View Article : Google Scholar
|
|
5
|
Guerriero S, Alcazar JL, Pascual MA,
Ajossa S, Olartecoechea B and Hereter L: Preoperative diagnosis of
metastatic ovarian cancer is related to origin of primary tumor.
Ultrasound Obstet Gynecol. 39:581–586. 2012.PubMed/NCBI View Article : Google Scholar
|
|
6
|
Gagnon Y and Têtu B: Ovarian metastases of
breast carcinoma. A clinicopathologic study of 59 cases. Cancer.
64:892–898. 1989.PubMed/NCBI View Article : Google Scholar
|
|
7
|
Bigorie V, Morice P, Duvillard P, Antoine
M, Cortez A, Flejou JF, Uzan S, Darai E and Barranger E: Ovarian
metastases from breast cancer: Report of 29 cases. Cancer.
116:799–804. 2010.PubMed/NCBI View Article : Google Scholar
|
|
8
|
Tserkezoglou A, Kontou S, Hadjieleftheriou
G, Apostolikas N, Vassilomanolakis M, Sikiotis K, Salamalekis E,
Tseke P and Magiakos G: Primary and metastatic ovarian cancer in
patients with prior breast carcinoma. Pre-operative markers and
treatment results. Anticancer Res. 26:2339–2344. 2006.PubMed/NCBI
|
|
9
|
Yamanishi Y, Koshiyama M, Ohnaka M, Ueda
M, Ukita S, Hishikawa K, Nagura M, Kim T, Hirose M, Ozasa H and
Shirase T: Pathways of metastases from primary organs to the
ovaries. Obstet Gynecol Int. 2011(612817)2011.PubMed/NCBI View Article : Google Scholar
|
|
10
|
Ghoncheh M, Pournamdar Z and Salehiniya H:
Incidence and mortality and epidemiology of breast cancer in the
world. Asian Pac J Cancer Prev. 17:43–46. 2016.PubMed/NCBI View Article : Google Scholar
|
|
11
|
Ernst MF, van de Poll-Franse LV, Roukema
JA, Coebergh JW, van Gestel CM, Vreugdenhil G, Louwman MJ and Voogd
AC: Trends in the prognosis of patients with primary metastatic
breast cancer diagnosed between 1975 and 2002. Breast. 16:344–351.
2007.PubMed/NCBI View Article : Google Scholar
|
|
12
|
Stelow EB and Yaziji H:
Immunohistochemistry, carcinomas of unknown primary, and incidence
rates. Semin Diagn Pathol. 35:143–152. 2018.PubMed/NCBI View Article : Google Scholar
|
|
13
|
Studzinski Z and Zajewski W: Bilateral
metastatic ovarian tumors (Krukenberg's tumors) in the course of
stomach cancer. Arch Gynecol Obstet. 267:95–97. 2002.PubMed/NCBI View Article : Google Scholar
|
|
14
|
Kawakubo N, Okido M, Tanaka R, Mitsugi K,
Fukuhara M, Aishima S, Kato M and Ichimiya H: Pseudo-Meigs'
syndrome associated with breast cancer metastasis to both ovaries:
Report of a case. Surg Today. 40:1148–1151. 2010.PubMed/NCBI View Article : Google Scholar
|
|
15
|
Naito K, Oura S, Yasuoka H and Okamura Y:
A case of pseudo-meigs' syndrome associated with ovarian metastases
from breast cancer. J Breast Cancer. 15:474–477. 2012.PubMed/NCBI View Article : Google Scholar
|
|
16
|
Fujii M, Okino M, Fujioka K, Yamashita K
and Hamano K: Pseudo-Meigs' syndrome caused by breast cancer
metastasis to both ovaries. Breast Cancer. 13:344–348.
2006.PubMed/NCBI View Article : Google Scholar
|
|
17
|
Jung YE, Lee JW, Kim BG and Bae DS:
Ovarian metastasis from pulmonary adenocarcinoma. Obstet Gynecol
Sci. 56:341–344. 2013.PubMed/NCBI View Article : Google Scholar
|
|
18
|
Rosendahl M, Timmermans Wielenga V,
Nedergaard L, Kristensen SG, Ernst E, Rasmussen PE, Anderson M,
Schmidt KT and Andersen CY: Cryopreservation of ovarian tissue for
fertility preservation: No evidence of malignant cell contamination
in ovarian tissue from patients with breast cancer. Fertil Steril.
95:2158–2161. 2011.PubMed/NCBI View Article : Google Scholar
|
|
19
|
Peters IT, van Zwet EW, Smit VT, Liefers
GJ, Kuppen PJ, Hilders CG and Trimbos JB: Prevalence and risk
factors of ovarian metastases in breast cancer patients <41
years of age in the Netherlands: A nationwide retrospective cohort
study. PLoS One. 12(e0168277)2017.PubMed/NCBI View Article : Google Scholar
|
|
20
|
Bastings L, Beerendonk CC, Westphal JR,
Massuger LF, Kaal SE, van Leeuwen FE, Braat DD and Peek R:
Autotransplantation of cryopreserved ovarian tissue in cancer
survivors and the risk of reintroducing malignancy: A systematic
review. Hum Reprod Update. 19:483–506. 2013.PubMed/NCBI View Article : Google Scholar
|
|
21
|
Laifer S, Buscema J, Parmley TH and
Rosenshein NB: Ovarian cancer metastatic to the breast. Gynecol
Oncol. 24:97–102. 1986.PubMed/NCBI View Article : Google Scholar
|
|
22
|
Ayhan A, Guvenal T, Salman MC, Ozyuncu O,
Sakinci M and Basaran M: The role of cytoreductive surgery in
nongenital cancers metastatic to the ovaries. Gynecol Oncol.
98:235–241. 2005.PubMed/NCBI View Article : Google Scholar
|
|
23
|
Eitan R, Gemignani ML, Venkatraman ES,
Barakat RR and Abu-Rustum NR: Breast cancer metastatic to abdomen
and pelvis: Role of surgical resection. Gynecol Oncol. 90:397–401.
2003.PubMed/NCBI View Article : Google Scholar
|
|
24
|
Moore RG, Chung M, Granai CO, Gajewski W
and Steinhoff MM: Incidence of metastasis to the ovaries from
nongenital tract primary tumors. Gynecol Oncol. 93:87–91.
2004.PubMed/NCBI View Article : Google Scholar
|
|
25
|
Li CI, Anderson BO, Daling JR and Moe RE:
Trends in incidence rates of invasive lobular and ductal breast
carcinoma. JAMA. 289:1421–1424. 2003.PubMed/NCBI View Article : Google Scholar
|
|
26
|
Borst MJ and Ingold JA: Metastatic
patterns of invasive lobular versus invasive ductal carcinoma of
the breast. Surgery. 114:637–641; discussion 641-632.
1993.PubMed/NCBI
|
|
27
|
Lamovec J and Bracko M: Metastatic pattern
of infiltrating lobular carcinoma of the breast: An autopsy study.
J Surg Oncol. 48:28–33. 1991.PubMed/NCBI View Article : Google Scholar
|
|
28
|
Curtin JP, Barakat RR and Hoskins WJ:
Ovarian disease in women with breast cancer. Obstet Gynecol.
84:449–452. 1994.PubMed/NCBI
|
|
29
|
Simpkins F, Zahurak M, Armstrong D,
Grumbine F and Bristow R: Ovarian malignancy in breast cancer
patients with an adnexal mass. Obstet Gynecol. 105:507–513.
2005.PubMed/NCBI View Article : Google Scholar
|
|
30
|
Moore K, Colombo N, Scambia G, Kim BG,
Oaknin A, Friedlander M, Lisyanskaya A, Floquet A, Leary A, Sonke
GS, et al: Maintenance olaparib in patients with newly diagnosed
advanced ovarian cancer. N Engl J Med. 379:2495–2505.
2018.PubMed/NCBI View Article : Google Scholar
|
|
31
|
Robson M, Im SA, Senkus E, Xu B, Domchek
SM, Masuda N, Delaloge S, Li W, Tung N, Armstrong A, et al:
Olaparib for metastatic breast cancer in patients with a germline
BRCA mutation. N Engl J Med. 377:523–533. 2017.PubMed/NCBI View Article : Google Scholar
|
|
32
|
Economopoulou P, Dimitriadis G and Psyrri
A: Beyond BRCA: New hereditary breast cancer susceptibility genes.
Cancer Treat Rev. 41:1–8. 2015.PubMed/NCBI View Article : Google Scholar
|
|
33
|
NCCN Clinical Practice Guidelines in
Oncology Genetic/Familial High-Risk Assessment; Breast, Ovarian and
Pancreatic. Version 2.2021-November 20,2020.
|